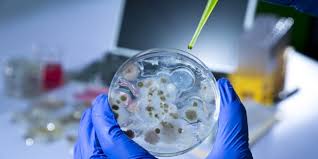

LAUDO LIMPEZA HIGIENIZAÇÃO AR CONDICIONADO VIGILÂNCIA SANITÁRIA
ELABORAMOS PMOC – PLANO DE MANUTENÇÃO ORIENTAÇÃO E CONTROLE DA PORTARIA 3.523 DO MINISTÉRIO DA SAÚDE, EXIGIDO PELA ANVISA REFERENTE A MANUTENÇÃO LIMPEZA E HIGIENIZAÇÃO NOS SISTEMA DE AR CONDICIONADO E CLIMATIZAÇÃO.
Todos os nossos procedimentos estão de acordo com a portaria 3.523do Ministério da Saúde e NR 09 do Ministério do Trabalho
INSTALAÇÃO MANUTENÇÃO CONSERTO
LIMPEZA HIGIENIZAÇÃO AR CONDICIONADO SPLIT
LAUDO VIGILÂNCIA SANITÁRIA AR CONDICIONADO COMÉRCIO INDÚSTRIA MARITIMO NAVAL ELABORAMOS PMOC – PLANO DE MANUTENÇÃO ORIENTAÇÃO E CONTROLE DA PORTARIA 3.523 DO MINISTÉRIO DA SAÚDE, EXIGIDO PELA ANVISA REFERENTE A MANUTENÇÃO LIMPEZA E HIGIENIZAÇÃO NOS SISTEMA DE AR CONDICIONADO E CLIMATIZAÇÃO. CONSULTA PELO CHAT, GENTILEZA INFORMAR NOME TELEFONE DE CONTATO E SE POSSÍVEL SEU E-MAIL, PRIMORDIAL PARA UM ATENDIMENTO RÁPIDO ATENDIMENTO DE 8:00 HS AS 18:00 HS ATENDIMENTO VILA VELHA ES VITORIA ES CARIACICA ES VIANA ES SERRA ES GUARAPARI ES 27 998030473 WhatsApp / Messenger VIVO 27 996197133 VIVO 27 992523102 CLARO RUY ROBSON grupovarejao@gmail.com QUEM TRABALHA DEUS AJUDA GRUPO VAREJÃO 15 ANOS
Saiba MaisLAUDO VIGILÂNCIA SANITÁRIA AR CONDICIONADO COMÉRCIO INDÚSTRIA MARITIMO NAVAL ELABORAMOS PMOC – PLANO DE MANUTENÇÃO ORIENTAÇÃO E CONTROLE DA PORTARIA 3.523 DO MINISTÉRIO DA SAÚDE, EXIGIDO PELA ANVISA REFERENTE A MANUTENÇÃO LIMPEZA E HIGIENIZAÇÃO NOS SISTEMA DE AR CONDICIONADO E CLIMATIZAÇÃO. 27 30723472 27 30631318 27 998030473 WhatsApp / Messenger VIVO 27 996197133 VIVO 27 996923299 RUY ROBSON grupovarejao@gmail.com QUEM TRABALHA DEUS AJUDA GRUPO VAREJÃO 15 ANOS
Saiba MaisLAUDO VIGILÂNCIA SANITÁRIA AR CONDICIONADO COMÉRCIO INDÚSTRIA MARITIMO NAVAL ELABORAMOS PMOC – PLANO DE MANUTENÇÃO ORIENTAÇÃO E CONTROLE DA PORTARIA 3.523 DO MINISTÉRIO DA SAÚDE, EXIGIDO PELA ANVISA REFERENTE A MANUTENÇÃO LIMPEZA E HIGIENIZAÇÃO NOS SISTEMA DE AR CONDICIONADO E CLIMATIZAÇÃO. CONSULTA PELO CHAT, GENTILEZA INFORMAR NOME TELEFONE DE CONTATO E SE POSSÍVEL SEU E-MAIL, PRIMORDIAL PARA UM ATENDIMENTO RÁPIDO ATENDIMENTO DE 8:00 HS AS 18:00 HS ATENDIMENTO VILA VELHA ES VITORIA ES CARIACICA ES VIANA ES SERRA ES GUARAPARI ES 27 30723472 27 30631318 27 998030473 WhatsApp / Messenger VIVO 27 996197133 VIVO 27 996923299 RUY ROBSON grupovarejao@gmail.com QUEM TRABALHA DEUS AJUDA GRUPO VAREJÃO 15 ANOS
Saiba MaisVárias páginas de promoção que lhe permitirão quebrar seções em seu site.